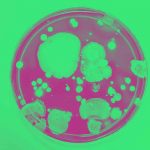

Language Stories
Learn all about the English language, from fun word facts and trivia to etymologies, meanings, histories, and more.

’90s vs. Now: How These Words Have Evolved

The Rosetta Stone: Unlocking Ancient Egypt

What Does Sudoku Mean In Japanese? And Other Sudoku Facts
-

“Bare” vs. “Bear”: What Is The Difference?
-

The Frabjous Words Invented By Lewis Carroll
-

What Do The Most Well-Known Website Names Mean?
-

“Hero” vs. “Protagonist:” What Is The Difference?
-

“On Line” vs. “In Line”: Which Do You Say?
-

“Ludicrous” vs. “Ridiculous”: How To Use Each Word
-

What Does The Letter “U” Have To Do With “W”?
-

What Does “ZIP Code” Stand For?
-

Canceled vs. Cancelled: Which Is Spelled Correctly?
-

Marshal vs. Martial: Do You Know The Difference?
-

“Pragmatic” vs. “Dogmatic”: What Are The Differences?
-

Lethologica vs. Lethonomia: What’s The Difference?
-
-

Deep Web vs. Dark Web: What’s The Difference?
-

Manslaughter vs. Murder: Difference In Intent And Degree
-

“Macaroon” vs. “Macaron”: What’s The Difference Between These Sweet Treats?
-

“Goth” vs. “Emo”: What’s The Difference?
-

“Especially” vs. “Specially”
-

“Uncharted” vs. “Unchartered”
-

“M.D.” vs. “Ph.D.” vs. “Dr.”: Are They Synonyms?
-

Disinfectant vs. Antiseptic: Understand The Difference
-

What Is The Difference Between “Furlough” vs. “Layoff”?
-

“Hoard” vs. “Horde”: Do You Know The Difference?
-

“Figuratively” vs. “Literally”
-

“Exercise” vs. “Exorcise”: What’s The Difference?
-
-

“Morbidity” vs. “Mortality”: What Is The Difference?
-

Introvert vs. Extrovert: What’s The Difference?
-
“Antibiotic” vs. “Abiotic” vs. “Antibody”: What Is The Difference?
-

“Climactic” vs. “Climatic”
-

“Virus” vs. “Bacteria”: What’s The Difference?
-

“Asymptomatic” vs. “Asymptotic” vs. “Asystematic”: Is There A Difference?
-

What’s the Difference Between “Sushi” vs. “Sashimi”?
-

What Is The Difference Between “Amid” vs. “Amidst”?
-

Is The Coronavirus A Plague?
-

Respirator vs. Ventilator: What Is The Difference?
-

What’s the Difference Between “Allude” vs. “Elude”?
-

“Amicable” vs. “Amiable”: What’s The Difference?
-
-

What’s the Difference Between “Afflict” vs. “Inflict”?
-

“Jury-rigged” vs. “Jerry-rigged”
-

Quarantine vs. Isolation: Is There A Difference?
-

“Latitude” vs. “Longitude”
-

“Ambiguous” vs. “Ambivalent”
-

Delegate vs. Superdelegate: What’s The Difference?
-

Words Coined In Each Decade Of The Last 100 Years
-

“Economic” vs. “Economical”
-

“Breach” vs. “Breech”: Don’t Confuse The Two!
-

What’s The Difference Between “Caucus” vs. “Primary”?
-

Where Did The Phrase “The Dog Ate My Homework” Come From?
-

Wary vs. Weary: How To Tell Them Apart